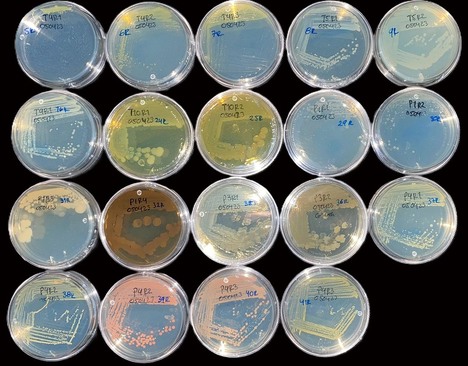

Sector | Protección de cultivos


Gartenbau-Versicherung
Una aseguradora alemana amplía su oferta para cultivos protegidos

“Tras la lucha integrada, la próxima revolución de las soluciones biológicas tendrá como foco el suelo”

República Dominicana:
Productores de invernadero en Ocoa reportan presión por trips y operativos migratorios

Actividades obligatorias ante el abandono de cosecha en el cultivo de la fresa

Piden a la UE “más valentía” en el reglamento Ómnibus para mejorar la lucha contra plagas y enfermedades

Nuevo envase de Aphidoletes-System mejora el control de áfidos
Biodiversidad y el control de plagas

¿Tomates con manchas negras? La bacteria causante de la “peca bacteriana” evoluciona hacia cepas más agresivas y evasivas

Fuente alternativa de alimentación para el establecimiento y desarrollo de los ácaros depredadores

Para organizaciones agrarias, pesqueras y de desarrollo rural
Publican la convocatoria de subvenciones 2026 en Andalucía

Daños y estrategias de control de la mosca blanca en los invernaderos

En Almería:
Ponen en marcha una nueva línea de financiación para agricultores de cultivos intensivos bajo plástico

El IFAPA traslada a jóvenes agricultores de Almería las innovaciones en control biológico de plagas

Texas sostiene su liderazgo en cultivos especializados

Solicitan a la Junta la ampliación del plazo para tramitar las ayudas por las borrascas

Otorgarán entre 5.000 y 25.000 euros por beneficiario
Comienza el plazo para aceptar la ayuda directa por las borrascas

La fauna auxiliar, pieza clave en la Gestión Integrada de Plagas

¿Cuál es la clave para un MIP eficaz?

Científicos prueban nueva tecnología para gestionar plagas en cultivos de frutas y hortalizas

Incrementan los cultivos en los que puede emplearse, tanto en invernadero como al aire libre
Anuncian ampliación de registro de acaricida autorizado para el control de ácaros tetraníquidos

Sinaloa intensifica el control de plagas en más de 800 mil hectáreas

La Comisión asigna 21,5 millones de euros en ayuda de emergencia a los agricultores de Bulgaria, Estonia y Hungría

Denuncian que la negativa del Ministerio al producto contra el pulgón cuesta el 50% de la cosecha a los afectados

El revestimiento antialgas de Multi-Cover demuestra su eficacia en un vivero en Países Bajos

Tendrán que comunicar expresamente la aceptación de la ayuda para poder percibirla
Publican una primera relación de más de 140.000 potenciales beneficiarios de las ayudas directas por las borrascas

Afecta especialmente cultivos de pimiento morrón, pepino y tomate
Plaga de trips reduce la producción hortícola bajo invernadero en República Dominicana

"Ante la volatilidad de los precios de la energía, la instalación de pantallas vuelve a cobrar protagonismo"

Nuevos pesticidas en China y América Latina buscan frenar la resistencia de plagas

Secretaría de Desarrollo Rural de Chihuahua, en México
Abren convocatoria para el aseguramiento de cosechas ante riesgos climáticos

IBMA
Destacan el papel del biocontrol y del manejo integrado de plagas ante el aumento de infestaciones de pulgón

Actualización del esquema de certificación PrimusGFS a su versión a la 4.0

Pulgones y moscas blancas: el dúo que dispersa el poleovirus en pimiento

MO-EL S.p.A. (Italia)
"Lygus en lechugas: hasta un 52% menos de daños con nuestras trampas"

Insisten en la "necesaria autorización de forma excepcional" de fitosanitarios eficaces en cultivo de tomate

Alemania:
Un desinfectante utilizado con éxito durante cuatro décadas celebra su aniversario

¿Cuánto puede generar por hectárea la protección contra la quemadura solar en huertos?

Plagas cuarentenarias detectadas en patatas, coles y tomates importados en Rusia

Una nueva amenaza para la horticultura
Alerta roja en el invernadero: el "Thrips parvispinus" aterriza en Italia

Boštjan Veronik, Director General de Waboost:
"Prevenir las condiciones que permiten que prospere el 'Pythium'"

Bioinsumos en la agricultura: con amebas desarrollan biofungicida para mildiú y oídio

Prácticas de detección y control del TSWV en cultivos de pimiento

Instan al Ministerio a autorizar el uso excepcional de spirotetramat ante la "indefensión" del sector frente al pulgón

Promueven el control biológico del picudo del chile en México

Validadas en ensayos con insectos vivos, demostrando eficacia contra plagas agrícolas clave
Plataforma de diseño de proteínas impulsada por IA para bioinsecticidas

Las ayudas benefician a 407 organizaciones en 15 comunidades autónomas
España solicita a la UE 413 millones para financiar a productores de frutas y hortalizas

Preocupación del sector por la pérdida de más de 6.000 hectáreas
Crean un protocolo para anticiparse en el control fitosanitario de los cultivos

De la crisis al crecimiento con la ayuda de nanoburbujas de oxígeno

Los cambios permitirán que obtengan apoyos un mayor número de solicitudes
El Plan Estratégico de la PAC contempla una dotación de 100 millones de euros entre 2025 y 2027

Costa Rica detecta el hongo "Neopestalotiopsis" en cultivos de fresa

El enfoque basado en datos de Berry Hill permite obtener cosechas récord de fresas en Jalisco

Soluciones eficaces ante un nuevo escenario de presión
Estrategia para el control de "Nasonovia ribisnigri" en lechuga

IBMA Spain
Mitos y Realidades de los Productos de Biocontrol

Mallas antiinsectos más fáciles de instalar y mejor protección contra las inclemencias invernales

Alerta en el campo murciano y andaluz: el pulgón amenaza cultivos hortícolas y la rentabilidad del sector

"Ya empezamos a sentir la escasez de plástico"
Pérdidas catastróficas en invernaderos y cultivos de Souss-Massa

“Este producto permitirá acabar con esta plaga de forma eficaz como ya se ha comprobado”
Solicitan autorización para fitosanitario contra pulgón en Almería

Un estudio busca contribuir al registro de pesticidas menos tóxicos de origen natural

Koppert presenta Limonica Ulti-Mite

El momento de la suelta de los insectos puede ser un factor muy importante al crear un programa de biocontrol
"Una liberación beneficiosa bien programada puede ahorrar semanas de frustración"

"Han sufrido daños por el inédito tren de borrascas que ha azotado el territorio andaluz"
Cumplen con su compromiso de respaldar a los productores del sector primario

Cuestionan supuestos históricos en fitopatología
Nuevos hallazgos estructurales sobre efectores de "Phytophthora"

Agroseguro activa los abonos iniciales y acelera las peritaciones
Cifran en 50 millones las indemnizaciones por el tren de borrascas, con 70.000 hectáreas siniestradas

Los campos de tomate brasileños se enfrentan a una creciente presión de plagas en Itapeva

Empresa amplía su presencia en México como mercado estratégico en biosoluciones agrícolas

"En las zonas de canalón donde se instalaron, no detectamos poblaciones de araña roja"
Integración de las plantas medicinales y aromáticas en la gestión integrada de plagas en invernaderos

En España:
El MAPA abre el plazo para comunicar los daños causados por las borrascas en caminos agrarios y regadíos

En HortiContact:
Presentan una nueva chinche depredadora y un sistema para la distribución de huevos de crisopa

La Comisión Europea modifica los LMR de varios plaguicidas a partir de este año

Un nuevo enfoque computacional que impulsa el desarrollo de biofungicidas

Basei Mg, la nueva solución natural de acción fungicida de Seipasa

La técnica es tres veces más eficaz que productos comerciales y con menos impacto ambiental
Desarrollan un bioherbicida con nanotecnología a partir de un cardo silvestre

La UE extiende uso de spinosad hasta 2041

“La tranquilidad de saber que por la noche estás eliminando la 'Tuta' de tus invernaderos no tiene precio”

Estos documentos del IFAPA proponen estrategias de manejo para mitigar daños
Publican siete guías de recomendaciones para los cultivos tras las inundaciones y episodios de lluvias extremas

“Cultivos más fuertes con soluciones basadas en extractos vegetales sin poner en riesgo a los polinizadores”

Michael Abraham, de Ektar by IDMAT
¿El refugio climático como nuevo seguro para las cosechas?

La plaga microscópica que reduce las cosechas de fresa hasta en un 80%

Programa de control de la "Tuta absoluta" en Nigeria
La plaga que causa pérdidas de hasta el 100% en campos de cultivo de tomate no tratados

COAG Andalucía reclama un plan extraordinario de ayudas directas y reconstrucción tras los daños por las borrascas

Una investigación revela cómo las hormigas afectan el control biológico del pulgón en pimiento

El control biológico de plagas se utiliza en el 94% de los cultivos de invernadero en los Países Bajos

Recomendaciones ante el riesgo de enfermedades fúngicas en cultivos hortícolas protegidos de Andalucía

Innovación en lechuga: Resistencia a Nasonovia Nr:1 (HR)

Hacia una gestión sustentable de los envases vacíos de plaguicidas en México

Mycotal ya está registrado en Alemania:
"Control fiable de la mosca blanca incluso a bajas temperaturas"

Convenio en México para el manejo de plagas en invernaderos

Leguminosas: ciencia aplicada que regenera suelos y fortalece la resiliencia agrícola

Descubren nuevas propiedades de sustancias naturales para controlar el pulgón en cultivos hortícolas

El sector pakistaní del tomate se enfrenta a riesgos de contaminación por metales pesados

¿Qué son los oligosacáridos de quitina y por qué se consideran “vacunas” vegetales?

Los herbicidas hormonales y los desafíos de su uso en Argentina

Innovaciones robóticas en Francia protegen cultivos de lluvias intensas y aumentan rendimiento

Nueva aplicación “Beesound” identifica abejas nativas por su zumbido para potenciar la polinización en frutales
¿Puede la tecnología mejorar la identificación de polinizadores efectivos?

Entre las aplicaciones potenciales, destaca la generación de bioinsumos para la agricultura
Una unidad pionera en América Latina se dedica al rescate y la preservación de los microorganismos nativos de Chile

Arrigoni Group renueva su identidad visual

NEVAL
"Nuestra meta es clara: ayudar a que las soluciones que llegan al mercado estén respaldadas por datos sólidos, comparativos y creíbles"

Contará con un presupuesto de 4.897 millones de euros para esta campaña
